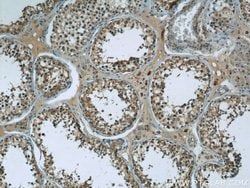
Img

50-173-4460
PHF2 Rabbit anti-Human, Polyclonal, Proteintech
Manufacturer: Proteintech Group Inc
Select a Size
| Pack Size | SKU | Availability | Price |
|---|---|---|---|
| Each of 1 | 50-173-4460-Each-of-1 | In Stock | ₹ 44,150.23 |
50-173-4460 - Each of 1
In Stock
Quantity
1
Base Price: ₹ 44,150.23
GST (18%): ₹ 7,947.041
Total Price: ₹ 52,097.271
Antigen
PHF2
Classification
Polyclonal
Conjugate
Unconjugated
Gene
PHF2
Gene Alias
GRC5, JHDM1E, KIAA0662, PHD finger protein 2, PHF2
Host Species
Rabbit
Purification Method
Antigen Affinity Chromatography
Regulatory Status
RUO
Gene ID (Entrez)
5253
Content And Storage
-20°C
Form
Liquid
Applications
Immunohistochemistry (Paraffin), Immunoprecipitation, Western Blot
Concentration
0.37 mg/mL
Formulation
PBS with 50% glycerol and 0.1% sodium azide; pH 7.3
Gene Accession No.
O75151
Gene Symbols
PHF2
Immunogen
PHF2 Fusion Protein Ag20257
Quantity
150 μL
Primary or Secondary
Primary
Target Species
Human
Product Type
Antibody
Isotype
IgG
Description
- This gene encodes a protein which contains a zinc finger-like PHD (plant homeodomain) finger, distinct from other classes of zinc finger motifs, and a hydrophobic and highly conserved domain
- The PHD finger shows the typical Cys4-His-Cys3 arrangement
- PHD finger genes are thought to belong to a diverse group of transcriptional regulators possibly affecting eukaryotic gene expression by influencing chromatin structure.
Compare Similar Items
Show Difference
Antigen: PHF2
Classification: Polyclonal
Conjugate: Unconjugated
Gene: PHF2
Gene Alias: GRC5, JHDM1E, KIAA0662, PHD finger protein 2, PHF2
Host Species: Rabbit
Purification Method: Antigen Affinity Chromatography
Regulatory Status: RUO
Gene ID (Entrez): 5253
Content And Storage: -20°C
Form: Liquid
Applications: Immunohistochemistry (Paraffin), Immunoprecipitation, Western Blot
Concentration: 0.37 mg/mL
Formulation: PBS with 50% glycerol and 0.1% sodium azide; pH 7.3
Gene Accession No.: O75151
Gene Symbols: PHF2
Immunogen: PHF2 Fusion Protein Ag20257
Quantity: 150 μL
Primary or Secondary: Primary
Target Species: Human
Product Type: Antibody
Isotype: IgG
Antigen:
PHF2
Classification:
Polyclonal
Conjugate:
Unconjugated
Gene:
PHF2
Gene Alias:
GRC5, JHDM1E, KIAA0662, PHD finger protein 2, PHF2
Host Species:
Rabbit
Purification Method:
Antigen Affinity Chromatography
Regulatory Status:
RUO
Gene ID (Entrez):
5253
Content And Storage:
-20°C
Form:
Liquid
Applications:
Immunohistochemistry (Paraffin), Immunoprecipitation, Western Blot
Concentration:
0.37 mg/mL
Formulation:
PBS with 50% glycerol and 0.1% sodium azide; pH 7.3
Gene Accession No.:
O75151
Gene Symbols:
PHF2
Immunogen:
PHF2 Fusion Protein Ag20257
Quantity:
150 μL
Primary or Secondary:
Primary
Target Species:
Human
Product Type:
Antibody
Isotype:
IgG
Antigen: C17orf46
Classification: Polyclonal
Conjugate: Unconjugated
Gene: SPATA32
Gene Alias: C17orf46
Host Species: Rabbit
Purification Method: Antigen Affinity Chromatography
Regulatory Status: RUO
Gene ID (Entrez): 124783
Content And Storage: -20°C
Form: Liquid
Applications: Immunohistochemistry (Paraffin), Western Blot
Concentration: 0.33 mg/mL
Formulation: PBS with 50% glycerol and 0.1% sodium azide; pH 7.3
Gene Accession No.: Q96LK8
Gene Symbols: SPATA32
Immunogen: C17orf46 Fusion Protein Ag18239
Quantity: 150 μL
Primary or Secondary: Primary
Target Species: Human
Product Type: Antibody
Isotype: IgG
Antigen:
C17orf46
Classification:
Polyclonal
Conjugate:
Unconjugated
Gene:
SPATA32
Gene Alias:
C17orf46
Host Species:
Rabbit
Purification Method:
Antigen Affinity Chromatography
Regulatory Status:
RUO
Gene ID (Entrez):
124783
Content And Storage:
-20°C
Form:
Liquid
Applications:
Immunohistochemistry (Paraffin), Western Blot
Concentration:
0.33 mg/mL
Formulation:
PBS with 50% glycerol and 0.1% sodium azide; pH 7.3
Gene Accession No.:
Q96LK8
Gene Symbols:
SPATA32
Immunogen:
C17orf46 Fusion Protein Ag18239
Quantity:
150 μL
Primary or Secondary:
Primary
Target Species:
Human
Product Type:
Antibody
Isotype:
IgG
Antigen: LY6G5C
Classification: Polyclonal
Conjugate: Unconjugated
Gene: LY6G5C
Gene Alias: C6orf20, G5c, LY6G5C, LY6G5CA, LY6G5CB, NG33
Host Species: Rabbit
Purification Method: Antigen Affinity Chromatography
Regulatory Status: RUO
Gene ID (Entrez): 114652, 80741
Content And Storage: -20°C
Form: Liquid
Applications: Immunoprecipitation, Western Blot
Concentration: 0.23 mg/mL
Formulation: PBS with 50% glycerol and 0.1% sodium azide; pH 7.3
Gene Accession No.: Q5SRR4, Q8K1T5
Gene Symbols: LY6G5C
Immunogen: LY6G5C Fusion Protein Ag18812
Quantity: 150 μL
Primary or Secondary: Primary
Target Species: Human, Mouse
Product Type: Antibody
Isotype: IgG
Antigen:
LY6G5C
Classification:
Polyclonal
Conjugate:
Unconjugated
Gene:
LY6G5C
Gene Alias:
C6orf20, G5c, LY6G5C, LY6G5CA, LY6G5CB, NG33
Host Species:
Rabbit
Purification Method:
Antigen Affinity Chromatography
Regulatory Status:
RUO
Gene ID (Entrez):
114652, 80741
Content And Storage:
-20°C
Form:
Liquid
Applications:
Immunoprecipitation, Western Blot
Concentration:
0.23 mg/mL
Formulation:
PBS with 50% glycerol and 0.1% sodium azide; pH 7.3
Gene Accession No.:
Q5SRR4, Q8K1T5
Gene Symbols:
LY6G5C
Immunogen:
LY6G5C Fusion Protein Ag18812
Quantity:
150 μL
Primary or Secondary:
Primary
Target Species:
Human, Mouse
Product Type:
Antibody
Isotype:
IgG
Antigen: TARSL2
Classification: Polyclonal
Conjugate: Unconjugated
Gene: TARSL2
Gene Alias: TARSL2, Threonine tRNA ligase, ThrRS
Host Species: Rabbit
Purification Method: Antigen Affinity Chromatography
Regulatory Status: RUO
Gene ID (Entrez): 123283
Content And Storage: -20°C
Form: Liquid
Applications: Immunocytochemistry, Immunofluorescence, Western Blot
Concentration: 0.19 mg/mL
Formulation: PBS with 50% glycerol and 0.1% sodium azide; pH 7.3
Gene Accession No.: A2RTX5
Gene Symbols: TARSL2
Immunogen: TARSL2 Fusion Protein Ag18298
Quantity: 150 μL
Primary or Secondary: Primary
Target Species: Human
Product Type: Antibody
Isotype: IgG
Antigen:
TARSL2
Classification:
Polyclonal
Conjugate:
Unconjugated
Gene:
TARSL2
Gene Alias:
TARSL2, Threonine tRNA ligase, ThrRS
Host Species:
Rabbit
Purification Method:
Antigen Affinity Chromatography
Regulatory Status:
RUO
Gene ID (Entrez):
123283
Content And Storage:
-20°C
Form:
Liquid
Applications:
Immunocytochemistry, Immunofluorescence, Western Blot
Concentration:
0.19 mg/mL
Formulation:
PBS with 50% glycerol and 0.1% sodium azide; pH 7.3
Gene Accession No.:
A2RTX5
Gene Symbols:
TARSL2
Immunogen:
TARSL2 Fusion Protein Ag18298
Quantity:
150 μL
Primary or Secondary:
Primary
Target Species:
Human
Product Type:
Antibody
Isotype:
IgG